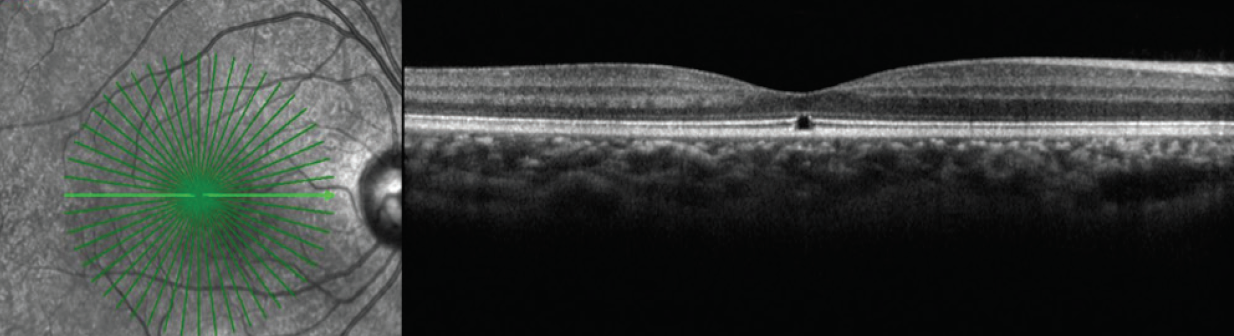
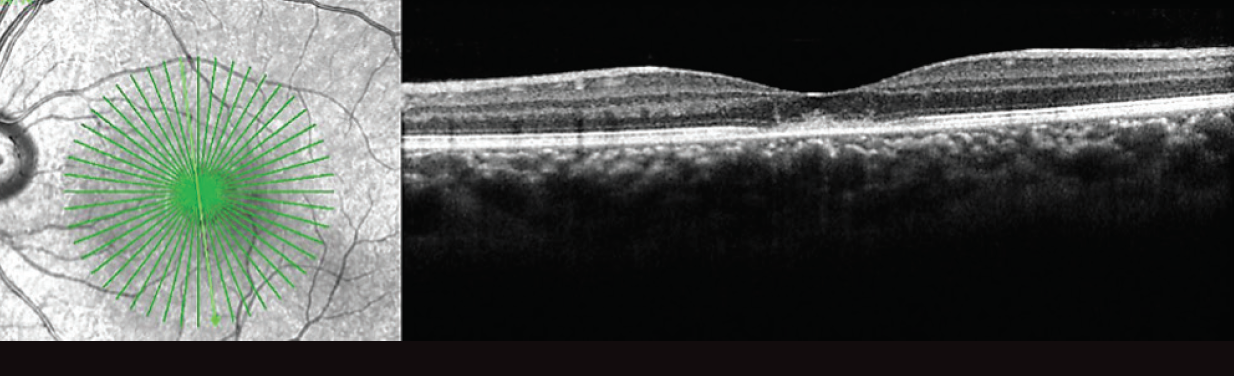

Acute vision loss can stem from a variety of causes, some common and some rare, and it can lead to long-term visual consequences; therefore, it is important to establish a diagnosis in order to determine the appropriate course of action. In this article we report the case of a patient who presented with acute unilateral vision loss.
CASE REPORT
An 18-year-old woman presented with a chief complaint of 2 weeks of painless vision loss in her left eye (OS). She reported no subjective change in her right eye (OD). The patient was born in Cape Verde, and her ocular history included a diagnosis of solar retinopathy diagnosed 3 years prior to this presentation (Figure 1). Her medical history was significant for polycystic ovarian syndrome, which was being treated with medroxyprogesterone.

Figure 1. OCT of the patient’s right (A) and left (B) eyes 3 years prior to presentation. The presence of focal subfoveal ellipsoid defects led to a diagnosis of solar retinopathy at that time.

Figure 2. Fundus photo OD demonstrates focal hypopigment-ation at the fovea consistent with the patient’s prior diagnosis of solar retinopathy (A). Fundus photo OS reveals a well-circumscribed central granular yellow lesion (B).
Baseline visual acuity before this presentation was 20/25 in each eye (OU). At this visit, her visual acuity OS had decreased to 20/400. Anterior segment examination was notable for an absence of inflammation. Funduscopic exam OD revealed focal hypopigmentation at the fovea (Figure 2A), and spectral-domain optical coherence tomography (OCT) demonstrated a focal defect involving the outer retina and ellipsoid layer, which was stable from 3 years prior (Figure 3). Fundoscopic exam OS was notable for absence of any posterior segment inflammation and a circumscribed central granular yellow lesion (Figure 2B). OCT revealed disruption of the subfoveal ellipsoid layer, hyperreflective debris involving the outer retina and apical surface of the retinal pigment epithelium (RPE), and a thickened choroid OS (Figure 4). Fluorescein angiography (FA) OS demonstrated early central hypofluorescence and parafoveal patchy hyperfluorescence without leakage (Figure 5). Electroretinography (ERG) demonstrated normal amplitudes OD and reduction of macular sensitivity OS.
Figure 3. OCT demonstrates a focal defect OD involving the outer retina and ellipsoid layer, which is consistent with the patient’s previous diagnosis of solar retinopathy.
Figure 4. OCT reveals disruption of the subfoveal ellipsoid layer OS and hyperreflective debris on the apical surface of the RPE.

Figure 5. Early (A) and late (B) FA images OS demonstrate early central hypofluorescence with parafoveal patchy hyperfluorescence without leakage.

Figure 6. Fundus photographs taken 6 months after presentation. OD is unchanged from presentation and demonstrates focal central hypopigmentation due to solar retinopathy (A). OS shows central RPE changes with dramatic improvement from presentation (B).
MAKING THE DIAGNOSIS
Acute unilateral loss of vision with associated central RPE changes in a previously healthy young woman is most consistent with an inflammatory maculopathy. The differential diagnosis includes unilateral acute idiopathic maculopathy, acute macular neuroretinopathy, and the white dot syndromes, most notably multiple evanescent white dot syndrome (MEWDS).

Figure 7. OCT 6 months after presentation shows a return to baseline OS with a focal outer retinal defect consistent with the patient’s prior diagnosis of solar retinopathy. There has been restoration of the remaining ellipsoid zone and resolution of the subretinal hyperreflective material that was noted on the earlier scan.
When the patient returned for follow-up 1 week later, her visual acuity had improved to 20/60 OS without intervention. She was asked to return in 1 month but did not return until 6 months later, at which time her visual acuity had improved to 20/30 OS. On funduscopic exam, the central yellow lesion had improved (Figure 6). The patient’s OCT returned to baseline OS and was notable only for the focal outer retinal defect symmetric with her other eye and stable from her exam 3 years earlier (Figure 7).
The funduscopic and OCT findings in this case, along with the patient’s spontaneous recovery, led to a diagnosis of unilateral acute idiopathic maculopathy (UAIM).
HISTORY OF UAIM
Yannuzzi first described UAIM in a series of nine patients who experienced sudden, severe unilateral visual acuity loss followed by spontaneous resolution with near-complete recovery of vision.1 In that original series, visual acuity loss was preceded by a flu-like illness in seven of nine patients. Visual acuity on presentation is typically 20/200 or worse.1 Early funduscopic findings include unilateral circumscribed pigmentary changes, which may or may not be associated with a neurosensory retinal detachment. Jung and colleagues2 and Nicolo and colleagues3 reported cases in which a neurosensory retinal detachment was seen within 48 hours of symptom onset and improved over the first week. FA often reveals early irregular hyperfluorescence and may demonstrate late leakage or pooling in the setting of subretinal fluid.
AT A GLANCE
• Sudden unilateral vision loss and spontaneous recovery associated with characteristic funduscopic and OCT changes in a young woman may be consistent with a diagnosis of unilateral acute idiopathic maculopathy (UAIM).
• Patients may report a preceding flu-like illness or more specific manifestations of coxsackievirus infection; coxsackie viral titers may help support a diagnosis in suspected cases of UAIM.
DISCUSSION
The case described here demonstrates classic OCT findings seen in UAIM, with heterogeneous hyperreflective thickening at the level of the outer retina and RPE resulting in disruption of the ellipsoid layer.3,4 On OCT at follow-up, the outer retinal layers were restored, which corresponded with visual recovery.
UAIM has been previously associated with coxsackievirus infection, leading some authors to speculate whether this supposedly idiopathic maculopathy should be renamed coxsackievirus maculopathy.5 Patients may report a preceding flu-like illness or more specific manifestations of coxsackie virus infection such as hand, foot, and mouth disease; orchitis; or epididymitis.2,5 It is notable that our patient presented with vision loss during the summer. Jung and colleagues suggested that UAIM may be more prevalent in the summer and fall, corresponding to higher rates of coxsackievirus transmission.2 Although not done in this patient, checking coxsackie viral titers may be helpful in supporting the diagnosis in suspected cases of UAIM.
WHEN TO CONSIDER UAIM
The funduscopic and OCT findings in our patient led to a diagnosis of UAIM. However, a number of atypical features should be noted, including the historical diagnosis of solar retinopathy, the lack of preceding viral illness, and the unremarkable FA. For this reason, other diagnoses were considered. It was suggested that the OCT findings might also have been consistent with MEWDS. However, given the lack of white dots, a diagnosis of UAIM was favored. MEWDS, like UAIM, is typically a disease that affects young, healthy people in a unilateral fashion and resolves without sequelae. In actuality, distinguishing between these inflammatory conditions that affect the RPE and/or choroid may be a matter of semantics.
The patient described above experienced sudden unilateral vision loss and spontaneous recovery associated with characteristic funduscopic and OCT changes in a young woman consistent with a diagnosis of UAIM. UAIM is a rare disease that should be considered in the differential diagnosis when evaluating patients with acute monocular vision loss.
1. Yannuzzi LA, Jampol LM, Rabb MF, Sorenson JA, Beyrer C, Wilcox LM Jr. Unilateral acute idiopathic maculopathy. Arch Ophthalmol. 1991;109(10):1411-1416.
2. Jung CS, Payne JF, Bergstrom CS, et al. Multimodality diagnostic imaging in unilateral acute idiopathic maculopathy. Arch Ophthalmol. 2012;130(1):50-56.
3. Nicolo M, Rosa R, Musetti D, et al. Early swept-source optical coherence tomography angiography findings in unilateral acute idiopathic maculopathy. Ophthalmic Surg Lasers Imaging Retina. 2016;47(2):180-182.
4. Matsushita E, Fukuda K, Nakahira A, et al. Resolution of photoreceptor outer segment damage in a patient with unilateral acute idiopathic maculopathy observed using spectral-domain optical coherence tomography. Graefes Arch Clin Exp Ophthalmol. 2012;250(5):765-768.
5. Beck AP, Jampol LM, Glaser DA, Pollack JS. Is coxsackievirus the cause of unilateral acute idiopathic maculopathy? Arch Ophthalmol. 2004;122(1):121-123.
Jordana G. Fein, MD, MS
• retina specialist at The Retina Group of Washington in Fairfax, Va.; cofounder of The International Society for the Advancement of Medical Retina
• financial interest: none acknowledged
• jfein@rgw.com
Richard A. Garfinkel, MD
• retina specialist at The Retina Group of Washington in Chevy Chase, Md., and in Fairfax, Va.
• financial interest: none acknowledged
• rgarfinkel@rgw.com
Joshua D. Levinson, MD
• first-year retina fellow at The Retina Group of Washington, Washington Hospital Center, Georgetown University Hospital program in Washington, D.C.
• financial interest: none acknowledged
• jlevinson@rgw.com
















